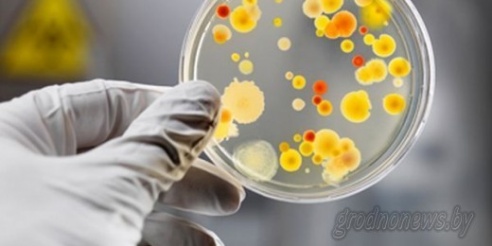

Личная территория
Хотите узнать больше? Зазвонил мобильный. В трубке послышался приятный женский голос: – Жанна Вацлавовна, добрый день. Мы приглашаем вас принять участие в презентации

Агроэкотуризм: далеко не туризм, и совсем мало агро
Хотите узнать больше? В погоне за длинным рублем, к сожалению, некоторые забывают, что агроэкотуризм – нечто другое, чем просто аренда коттеджа под банкеты. Бизнес

«Песнь песней» в исполнении гродненского художника
Хотите узнать больше? Уникальные книги ручной работы «Песнь песней царя Соломона» на английском и итальянском языках с офортами Юрия Яковенко презентовали в Гродненском

Новая история столетнего дворца
Хотите узнать больше? Дворец князей Святополк-Четвертинских в Желудке наконец-то обрел новых хозяев. Его с аукциона купила московская семья. Мы побывали в старинной
Из ресторана в больницу
Хотите узнать больше? Посетив ресторан, на больничные койки с диагнозом сальмонеллез попало больше десятка граждан. Полтора месяца назад в ресторане «Колос» райцентра

Протянуть руку помощи
Хотите узнать больше? Первый школьный звонок для первоклассницы Анастасии Скворцовой из Донецкой области прозвучал в Скидельской гимназии. Девочка быстро нашла общий язык

В Ольшанке открыли новую школу
Хотите узнать больше? 13 первых классов начали учебный год в новой школе в микрорайоне Ольшанка в Гродно. Это хороший знак: в стране создаются все условия для достойного

Гродненский «Неман» впервые в истории выиграл Кубок Беларуси по хоккею
Хотите узнать больше? В финале турнира, носящего имя Руслана Салея, гродненцы уверенно переиграли столичную «Юность» -- 5:0! Победа в Кубке стала своеобразным ответом всем
Инфо
Расписание- Экспрессные автобусы
- Городские автобусы
- Маршруты городского транспорта
- Пригородные автобусы
- Междугородные автобусы
- Пригородные поезда
- Карта Гродно
- Карта Скиделя
- Карта Гродненского района
- Карта-схема движения городского транспорта Гродно
Объявления
Качественные металлические кровати, желе...
1 000 бел.руб.
18:09, 25.01.2023Оптом недорогие тумбы и стулья
1 000 бел.руб.
18:09, 25.01.2023Дом с саунойна часы-сутки в Гродно
150 бел.руб.
05:40, 09.12.2022Грузоперевозки до 3т мебельный фургон (4...
111 бел.руб.
16:02, 07.12.2022Вывозим мусор, любой хлам, мебель и т. д...
1 бел.руб.
16:02, 07.12.2022О Гродно
Почему в выходные дни тариф на пригородных маршрутах повышается?
Подробнее В выходные дни, когда большинство студентов едут к родителям, тариф на пригородных маршрутах повышается. Четверг. В ожидании автобуса Ошмяны–Сморгонь интересуюсь ...
Интересная Беларусь
Разрушаем образы миллионеров из соц сетей
Подробнее Очень часто мы видим рекламные блоки в социальных сетях, где молодые миллионеры предлагают нам заработать кучу денег. Обычно, это юные 20-25 летние парни, которые не брезгают похвастать своими



 Нет данных м/с
Нет данных м/с


